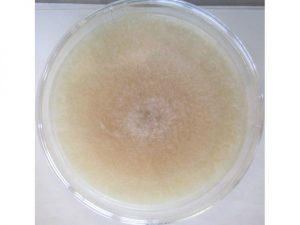
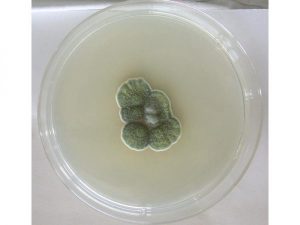

【監修者:管理栄養士 坂本圭子】
カレーは、一皿で野菜やお肉がとれる上に簡単に作れる、お助けメニューですよね。家族全員がおかわりするので、必ず多めに作ります!

でも、季節によっては腐りやすいのが悩みです。早い時には、作った当日中にカビが生えることも…。
カビの部分を取り除けば食べられるのでしょうか?カレーのカビについて、徹底調査してみました!
- 「カビ」・「カビ以外の変化」の見分け方が知りたい!うっすら白い膜もカビなの!?
- カレーにカビが生える原因とは?
- カビが生えたカレーの処理方法
- カレーが腐るとどうなるの?
- カレーを正しく保存して日持ちを長くしたい!保存方法を調査
カレーには黒い・緑・赤いなど、さまざまな色のカビが生えます。色が違うということは、原因も違うんですよね。
私が子供の頃は、祖母が「カビを取り除くと食べられる」・「カビを取ってしっかり加熱すれば大丈夫」なんてことを言っていました。
実際にカビを取ってグツグツと熱くしたカレーを食べたこともあるのですが、とても気持ち悪い味でした。
腐ってしまったカレーはもちろん食べられませんが、今回はカビの原因を徹底解明していきます!
わかりやすい画像も交えながら、カビが生えないようにする対策までをご紹介するので、ぜひ最後までごらん下さい。
記事監修・坂本圭子先生管理栄養士・栄養士
目次
カビの生えたカレーは食べられる?見分け方や発生原因を調査!
夏にカレーを作ったときのことですが、お昼に作って夕方に食べようとしたら、表面全体に白い膜が張っていたことがありました。

「お肉から出た油かな?」と思ったのですが、ムワッとする嫌な臭いがしたので、泣く泣く捨てました。
カレーに出るカビの原因を詳しく調べたので、ご紹介します。
カレーに生えるのはこんなカビ!原因は何?
カレーに生えるカビは、1種類ではありません。色ごとにカビの原因を調査したのですが、同じ色でも原因が違う場合がありました。
カビの原因の1例を、画像と一緒にご紹介していきます。
白いカビ
カレー鍋のフタを開けたときに、表面全体が白い膜(しわしわしていることもある)に覆われていると、びっくりしますよね。
これは空気中の雑菌が原因です。さらに時間がたつと赤に変色していきます。
増殖が早いので、カレーを作った1日目でも出ることがあります。
黒いカビ
カレーの表面の一部に黒く集合して見えるカビは、湿気や空気中の汚れが原因です。

緑のカビ
カレーの表面の一部に集合している緑のカビは、空気中の雑菌が原因です。
ご紹介してきたカビは、空気中や湿気中に漂っているものでしたね!なぜカレーにカビが生えやすいのかが疑問でしたが、下記の「カビが活発に増殖する環境」を知って納得しました。
カビが増殖しやすい環境
-
- 温度:20~30℃
- 湿度:70~80%以上
- 水気やホコリがある場所

とろみがあるカレーは冷めにくいですし、フタをすると鍋の中の湿度が高くなります。

カレーに水気があるのはもちろん、作っている途中にホコリがつくのは避けられませんよね。カレー鍋の中は、雑菌にとって絶好の増殖環境になるんですね。
夏や梅雨時季なら、常温での保存環境はもっと悪くなります!
カレーのカビを取り除けば食べられるの?
多少の菌はどの食品にでもついていて、食べた場合も体に異変が出ないのが一般的です。
ただし、カビが目に”見えるほどに増殖”したカレーを食べるのは、おすすめできません。
カビの部分だけを取り除いても、カレーの中にはすでに増殖した雑菌がウヨウヨしています!
*カレーを放置するとカビが生えるだけではなく、加熱しても死滅しない食中毒菌が増殖する場合もあります。
後ほど「カレーは腐るとどうなるの?食中毒の見分け方や目安がコレ!」で詳しくご紹介します。
冷蔵庫保存したときの白い塊もカビなの?

カレーを冷やすと、表面に白い塊が出る場合があります。これがお肉から出た脂なら、食べてもOKです。
カビと脂の見分け方は、下記を参考にしてみて下さい。
| 見分けるポイント | カビ | 脂 |
| 見た目 | フワフワ | 固まっている |
| 触った感じ | 粉っぽい | ねっとりする |
カビが生えたカレーは、「変な臭い」や「粘り」などの異変も、一緒におこることが多いです。
脂は加熱すればいつも通り美味しく食べられますので、ぜひ厳しく見分けましょう。

カレーにカビが生える原因が分かったので、なるべく予防したいと思います!
とはいえ、カレーを無菌で作るのは無理ですよね。気をつけていてもカビが生えてしまった場合は、どのように処理をすればいいのでしょうか?
カレーにカビが生えた時の処理方法は?捨て方や鍋の洗い方を解説!
カレールーには、洗い流すのが面倒な脂がたくさん含まれています。排水溝にそのまま流すと、配水管が汚れてしまうことも…。
でもカレーをゴミに捨てると、臭いがすごいです!汁もれの心配もありますよね。臭いと汁もれを防ぐために、下記のような捨て方はいかがでしょうか?
腐ったカレーの捨て方
- 空の牛乳パックを用意する
- 牛乳パックの底に、使用済み油を吸い取るアイテムを入れる(薬局などで売っています)
- カレーを入れる
- カレーの上に新聞紙を詰める
- 新聞紙の上をガムテープでふさぐ
- 袋を二重にして、牛乳パックを入れる
- 袋の口をしっかり結んで捨てる
使用済み油を吸い取るアイテムは、下記のような商品です。なければ、キッチンペーパー何枚かをたたんで入れてもOKです。
我が家では牛乳をあまり飲まないので、我慢してゴミの日まで冷蔵庫に入れておきます。ゴミの日になったら、ビニール袋に入れて捨てていました。
ご家庭の状況に合わせて、捨て方を選んでみて下さい。
カビが生えたカレー鍋はこれからも使えるの!?
カビが生えたカレーを捨てたら、次の悩みは鍋をどうするかですよね。
鍋は、洗って使えるのでご安心下さい。カビの菌が残っていないか心配な場合は、下記の方法をお試し下さい!
- 鍋の脂が取れるまで、しっかり洗う
- 鍋を煮沸消毒する
- 鍋を塩素系漂白剤にひたす
- もう一度鍋を煮沸消毒する
下記のような場合は、カレー鍋に水をたっぷり入れてお湯をわかし、5~10分ほど沸騰状態を保って煮沸しましょう!
- 鍋にプラスチック部品(熱で溶ける部品)がついている場合
- カレー鍋よりも大きい鍋が無い場合
通常通り煮沸消毒をして問題が無い場合は、下記の動画が参考になります。
カレーにカビが生える原因と、カビが生えてしまったときの対処法がわかりました。
でも、まだ安心はできませんよね。カレーが食べられなくなるのは、カビが生えたときだけではありません!
次にカレーが腐った時の、カビ以外の症状をご紹介します。
カレーは腐るとどうなるの?食中毒の見分け方や目安がコレ!
カレーは、カビの発生以外にも食べられない状態になる場合があります!
カレーが腐るとどうなるのかはもちろん、腐っていなくても危険性がある食中毒菌についてもご紹介していきます。

こんなカレーは食べちゃダメ!カビ以外の危険な症状
カレーが腐るとどうなるのか、カビ以外の見分け方も知っておきましょう!
見た目
- 全体が白く濁る
- 表面に白い泡が出ている
- ルーがサラサラで水っぽい
臭い
- アンモニア臭
- 酸っぱい臭い
- 気持ち悪い臭い

味
- ルー・具材どちらも、糸をひくようにねばねばする
- 酸っぱい
- 気持ち悪くなるような変な味
先ほどご紹介したカビが増殖しやすい温度・湿度以外にも、下記が原因でカレーが腐るのが早くなる場合があります。
- カレーを寝かす目的で常温放置
- かたくなったカレールーをのばすために、牛乳を継ぎ足し
- 古い食材を使う
- スプーンやお玉に直接口をつけて味見 など

基本的に、少しでも変な感じがする場合は食べないのがおすすめです!
特に子どもさんや免疫力が低い方は、健康な方よりも雑菌の影響を受けやすいので、十分にご注意下さい。
余ったカレールーを久しぶりに使うとき、「使って大丈夫かな?」と不安になることは無いでしょうか?
こちらの記事で、カレールーについても詳しい情報をご紹介しています!
↓↓↓
固形カレールーの日持ちを調査!賞味期限切れはいつまで使えるの?
カビてなくても要注意!カレーが原因の食中毒
食品を食べるときには、カビなどの雑菌の他に食中毒菌にも注意する必要があります。

食中毒菌がついても、見た目・臭い・味が変化しないこともあるので、気づかずに感染してしまうのが怖いですね。
カレーにつく可能性がある食中毒菌の中で、特にご注意頂きたい「ウエルシュ菌」についてご紹介します。
ウエルシュ菌とは?
人や動物の腸内・土の中・水の中など、どこにでもいる菌で、下記のような特徴があります。
- 空気が無い場所が好き!カレー鍋の中は絶好の増殖環境
- 熱に強い
- 増殖が早い
ウエルシュ菌の予防方法

- カレーを調理中や温め直すときは、よく混ぜて全体に空気を入れる
- 低温で保存
ウエルシュ菌には死亡事例がなくて、感染した場合も下痢や腹痛など、比較的軽い症状ですむと言われています。
それでも、自分が作ったカレーで家族がお腹を壊すと思うと嫌ですよね。

最後にカレーの正しい保存方法もご紹介するので、腐らせる&食中毒どちらも、しっかり予防しましょう!
カレーがカビない保存方法とは?作り置きしたときの日持ち期間も解説
カレーが何日で腐るかは、保存環境に左右されます。
カレーが完成すると一息つきたいところですが、すぐに食べない場合は、保存のために動き始めましょう!

カビなどの雑菌・食中毒菌どちらも、予防できる最大のポイントは「低温保存」です。
ネット上には「毎日しっかり温め直せば、常温保存でもカビが生えずに日持ちするという」情報がありますが、必ず冷蔵庫か冷凍で保存なさって下さい。
冷蔵庫での保存方法(日持ちの目安:5日ほど)
- タッパーに小分けにするなどして、なるべく早く粗熱をとる
- タッパーなどに入れて、しっかりフタをする
- 冷蔵庫に入れる
冷蔵庫での保存中にも、注意して頂きたいポイントがあります。

- 保存容器のフタに水滴がついたら、拭き取る
- 清潔なスプーンなどで取り分ける
- 食べる分だけ温める
- 食べない分はすぐに冷蔵庫に戻す
「温める→冷ます→温める」を繰り返すと、その都度雑菌がつきます。
2日目や3日目でもカビが生える危険性が高まるので、「温めるのは食べる分だけ」にしましょう!
冷凍庫での保存方法(日持ちの目安:2週間ほど)
カレーを冷凍庫で保存すると、ルーも具材も食感が悪くなってしまいます。
*じゃがいもなど、冷凍に向かない食材もあります。

初めから「冷凍する」と分かっている場合は、具材を小さくカットして、ルーを多くしすぎないようおすすめします。

- カレーの粗熱を取る
- 1回食べる分ずつ、ジップロックなどの密閉できる保存袋に入れる
- 一度封をして、完全に冷ます
- 完全に冷めたら空気を抜いて密閉する
- 保存袋を平らにして、冷凍庫に入れる
冷凍したカレーを食べるときには、冷蔵庫にうつして自然解凍をした後に、鍋か電子レンジで温めて下さいね。
↓↓↓
レトルトカレーが賞味期限切れに!半年以上過ぎても食べられるの?
まとめ
カレーのカビについて、原因から予防するための保存方法までをご紹介してきました。
ポイントをまとめてみます!
- 空気中・湿気中には、さまざまな雑菌がいる
- 雑菌がカレーに付着して増殖すると、目に見えるほどのカビの集合になる
- 目に見えるほどカビが生えているカレーは、カビを取り除いても食べないのがおすすめ
- カビが生えたカレーは臭いを閉じ込めて、汁もれがないように注意して捨てる
- カレーが腐ると、カビ以外のさまざまな症状が出る
- 食中毒の危険性も忘れずに、正しく保存するのが大切
大鍋でたくさん作ったカレーにカビが生えるとショックですが、安全面を第一に考えて、もったいなくても捨てるのが大切でした。
捨てる際は、排水溝にカレールーを流すと、強い動物性の脂のせいで配水管が汚れてしまいます。
臭いなどを防止しながら、なるべくゴミに捨てて下さいね。
今回は、カビの原因が空気中や湿気中の雑菌だとわかりました。雑菌の増殖を抑えるために正しく保存するのは、食中毒菌の予防にもつながります。
作ったらなるべく早く低温の環境で保存して、これからもカレーを安全に・美味しく食べていきましょう!


